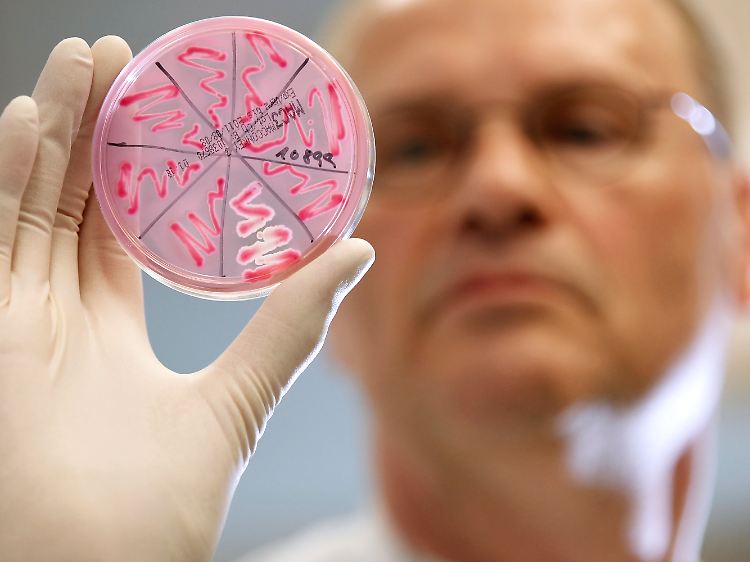
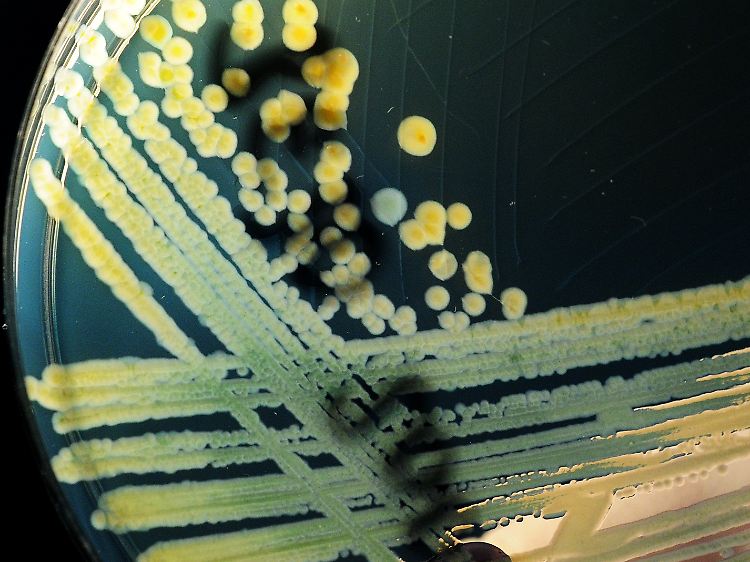

EHEC-Darmkeim breitet sich aus Mehr als 300 Fälle möglich
23.05.2011, 22:35 UhrDer lebensgefährliche Darmkeim EHEC macht immer mehr Menschen krank. 140 Fälle sind bereits bestätigt, einige schweben in Lebensgefahr. Mehr als 160 Verdachtsfälle werden noch geprüft. Aus Auslöser kommt ungewaschenes Gemüse in Frage. Die Infektionsquelle ist noch unklar. Gesundheitsexperten suchen unter Hochdruck.
Im mikrobiologischen Labor des Asklepios-Klinikums Hamburg-Altona: Petrischale mit einer EHEC-Bakterienkultur.
(Foto: dapd)
Der lebensgefährliche Darmkeim EHEC breitet sich immer weiter aus: Die Behörden in Deutschland haben bereits mehr als 300 bestätigte Erkrankungen oder Verdachtsfälle registriert. Der Erreger grassiert vor allem in Norddeutschland, taucht aber auch in anderen Bundesländern auf.
Mehrere Infizierte kämpfen um ihr Leben: Einige von ihnen wurden künstlich beatmet, ein Patient liegt nach Krämpfen im Koma. Insgesamt haben die Gesundheitsbehörden in Deutschland mindestens 140 Fälle registriert, darunter mehr als 40 besonders schwere. Und die Tendenz ist deutlich steigend. Mehr als 160 Verdachtsfälle müssen bundesweit noch geprüft werden.
"Das ist eine ernsthafte Krankheit, damit ist nicht zu spaßen", hieß es aus der Hamburger Gesundheitsbehörde. Vor allem die Häufung der schweren Fälle sei ungewöhnlich, meinte auch Arzt Jun Oh vom Hamburger Universitätsklinikum: "So heftig gab es das bisher kaum."
Auslöser könnte Gemüse sein

Der Erreger könnte sich auf Gemüse befinden.
(Foto: dpa)
Die Suche nach dem Auslöser hat bislang kaum Erkenntnisse gebracht. Unter Verdacht ist weiterhin ungewaschenes Gemüse. Die Angaben der Betroffenen lassen nach Angaben des Hamburger Institutes für Hygiene und Umwelt vermuten, dass die üblichen Verdächtigen wie Rohmilch, Frischkäse und Rindfleisch für den großen Ausbruch des Erregers ausscheiden. Die Patienten hätten wenig Fleisch gegessen.
In Frankfurt wurden indes zwei Kantinen einer Unternehmensberatung geschlossen, weil einige der betroffenen Patienten dort arbeiteten. Wahrscheinlich habe ein Lieferant kontaminierte Ware geliefert.
Betroffen sind überwiegend erwachsene Frauen. "Das legt nahe, dass vor allem Frauen Zugang zur Infektionsquelle haben", sagte der Präsident des niedersächsischen Landesgesundheitsamtes, Matthias Pulz, in Hannover. "Das Lebensmittel muss sich irgendwo im Handel befinden." Man sei auf der Suche nach der Nadel im Heuhaufen.
Infektionsquelle weiterhin unklar
Der Erreger kann auch durch das Gülle-Düngen von Obst und Gemüse in den Nahrungskreislauf gelangt sein. Dem Robert Koch-Institut (RKI) zufolge ist die Infektionsquelle möglicherweise noch aktiv.
Die mehr als 40 schweren Verläufe litten unter dem hämolytisch-urämischen Syndrom (HUS), das von dem Darmbakterium verursacht wird. Dabei kann es zu Nierenversagen, Blutarmut durch den Zerfall roter Blutkörperchen und einem Mangel an Blutplättchen kommen.
Die EHEC-Erkrankungen, die auch von blutigen Durchfällen begleitet seien, häuften sich seit der zweiten Maiwoche. Laut RKI treten weiterhin ständig neue Fälle auf. Ein RKI-Team ist derzeit in Hamburg, wo bislang rund 30 HUS-Fälle gemeldet wurden.
In Niedersachsen und Bremen sind 69 EHEC-Patienten bekannt. "Bei einigen besteht Lebensgefahr", sagte Pulz. In Hamburg liegt die Zahl bei 40 bestätigten Fällen. In Schleswig-Holstein lagen 90 Verdachtsfälle vor, darunter 13 mit besonders schwerem Verlauf.
Fälle breiten sich aus

Niedersachsens Gesundheitsministerin Aygül Özkan beantwortet in Hannover die Fragen der Journalisten.
(Foto: dpa)
In Hessen erkrankten nach offiziellen Angaben bislang 25 Menschen an dem EHEC-Keim. Mecklenburg-Vorpommern meldet vier bestätigte Fälle und Nordrhein-Westfalen drei. Im Saarland haben sich mindestens drei Menschen infiziert, zwei von ihnen liegen auf der Intensivstation. In Berlin gibt es zwei Verdachtsfälle. In Brandenburg, Sachsen, Sachsen-Anhalt, Thüringen, Rheinland-Pfalz, Baden-Württemberg und Bayern gab es am Montag keine bestätigten Erkrankungen.
Zu den Symptomen zählen Durchfall, Erbrechen, Übelkeit und Bauchschmerzen. Normalerweise sind vor allem Kleinkinder betroffen. Warum sich nun vor allem Erwachsene infizieren, ist unklar.
Die Erreger der EHEC-Infektion sind besondere Stämme der Escherichia coli-Bakterien. Sie leben vor allem im Darm von Wiederkäuern, insbesondere Rindern. Sie können über nicht erhitzte Lebensmittel übertragen werden. Auch eine Mensch-zu-Mensch-Übertragung ist bei mangelnder Hygiene möglich.
EHEC-Keime treten in Deutschland immer wieder auf. Das RKI hat seit Einführung der Meldepflicht 2001 bundesweit jährlich zwischen 800 und 1200 EHEC-Erkrankungen registriert, die aber oft einen leichteren Verlauf nahmen.
Quelle: ntv.de, dpa